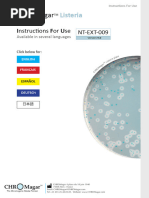

0% encontró este documento útil (0 votos)
43 vistas11 páginasInscripción Food Trucks Espinar 2024
Este documento es una ficha de inscripción para una feria internacional en Espinar, Perú en 2024. Contiene información sobre Lacteosol, una asociación que elabora una variedad de productos lácteos como quesos, yogurt, mantequilla y helados. Describe sus productos, historia, certificaciones y rango de precios. La persona de contacto es Wendy Quispe, gerente general de Lacteosol.
Cargado por
Anonymous ApzHRrQIFgDerechos de autor
© © All Rights Reserved
Nos tomamos en serio los derechos de los contenidos. Si sospechas que se trata de tu contenido, reclámalo aquí.
Formatos disponibles
Descarga como DOCX, PDF, TXT o lee en línea desde Scribd
0% encontró este documento útil (0 votos)
43 vistas11 páginasInscripción Food Trucks Espinar 2024
Este documento es una ficha de inscripción para una feria internacional en Espinar, Perú en 2024. Contiene información sobre Lacteosol, una asociación que elabora una variedad de productos lácteos como quesos, yogurt, mantequilla y helados. Describe sus productos, historia, certificaciones y rango de precios. La persona de contacto es Wendy Quispe, gerente general de Lacteosol.
Cargado por
Anonymous ApzHRrQIFgDerechos de autor
© © All Rights Reserved
Nos tomamos en serio los derechos de los contenidos. Si sospechas que se trata de tu contenido, reclámalo aquí.
Formatos disponibles
Descarga como DOCX, PDF, TXT o lee en línea desde Scribd